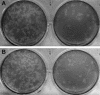

Reverse genetics system for porcine enteric calicivirus, a prototype sapovirus in the Caliciviridae
- PMID: 15650167
- PMCID: PMC544127
- DOI: 10.1128/JVI.79.3.1409-1416.2005
Reverse genetics system for porcine enteric calicivirus, a prototype sapovirus in the Caliciviridae
Erratum in
- J Virol. 2013 Jul;87(14):8266. Sosnovtsev, Stanislav S [corrected to Sosnovtsev, Stanislav V]
Abstract
A porcine enteric calicivirus (PEC), strain Cowden in the genus Sapovirus of the Caliciviridae family, can be propagated in a porcine kidney continuous cell line (LLC-PK) in the presence of bile acids in the cell culture medium. A full-length cDNA copy of the Cowden PEC genome was cloned into a plasmid vector directly downstream from the T7 RNA polymerase promoter, and capped RNA transcripts derived from this clone were infectious when transfected into LLC-PK cells. The recovery of PEC after transfection of RNA transcripts was dependent on the presence of bile acids, consistent with our recent identification of a bile acid-mediated signaling pathway required for PEC replication (Chang et al., Proc. Natl. Acad. Sci. USA 101:8733-8788, 2004). Recovery of virus was verified by detection of PEC antigen in transfected cells by immunofluorescence and enzyme-linked immunosorbent assays, direct observation of recovered viral particles by electron microscopy, and partial sequence analysis of their genomes (first 1,070 nucleotides) to differentiate them from tissue culture-adapted parental virus. The recovered virus retained its ability to infect piglets when administered by the oral route and showed an attenuated phenotype similar to that of the tissue culture-adapted parental virus. This reverse genetics system for PEC provides a new tool to study the molecular basis of replication and pathogenesis for caliciviruses associated with diarrheal disease.
Figures

References
-
- Chang, K. O., Y. Kim, K. Y. Green, and L. J. Saif. 2002. Cell-culture propagation of porcine enteric calicivirus mediated by intestinal contents is dependent on the cyclic AMP signaling pathway. Virology 304:302-310. - PubMed
-
- Chang, K. O., S. V. Sosnovtsev, G. Belliot, Y. Kim, L. J. Saif, and K. Y. Green. 2004. Bile acids are essential for porcine enteric calicivirus replication in association with down-regulation of signal transducer and activator of transcription 1. Proc. Natl. Acad. Sci. USA 101:8733-8788. - PMC - PubMed
-
- Clarke, I., and P. R. Lambden. 1997. The molecular biology of caliciviruses. J. Gen. Virol. 78:291-301. - PubMed
-
- Cubitt, D. 1994. Caliciviruses, p. 549-568. In A. Z. Kapikian (ed.), Viral infections of the gastrointestinal tract. Marcel Dekker Inc., New York, N.Y.
-
- Fankhauser, R. L., J. S. Noel, S. S. Monroe, T. Ando, and R. I. Glass. 1998. Molecular epidemiology of “Norwalk-like viruses” in outbreaks of gastroenteritis in the United States. J. Infect. Dis. 178:1571-1578. - PubMed
Publication types
MeSH terms
Substances
Grants and funding
LinkOut - more resources
Full Text Sources
Other Literature Sources

